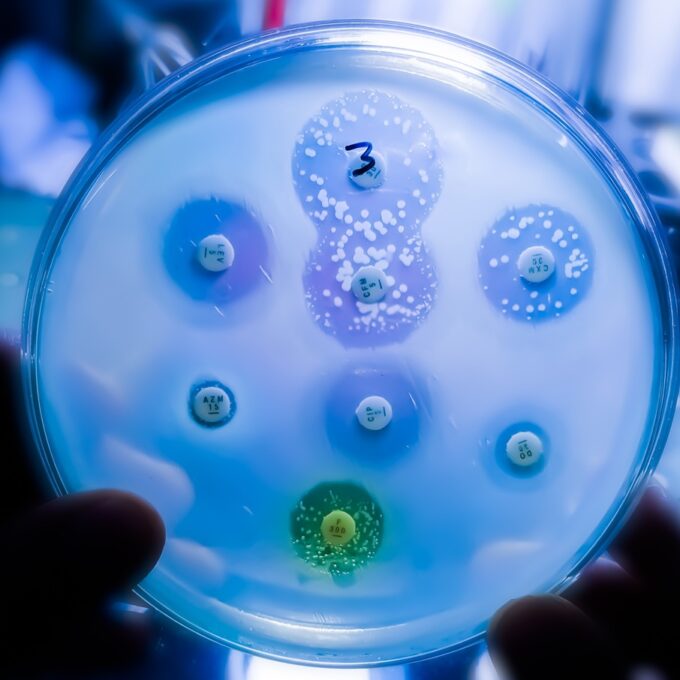

Volgens het ECDC sterven jaarlijks meer dan 35.000 mensen in de 27 EU-landen plus Noorwegen, IJsland en Liechtenstein (EER) aan infecties die niet meer goed te behandelen zijn. ‘Dat zijn geen abstracte cijfers’, zegt Peter Bertens, strategisch adviseur bij de Vereniging Innovatieve Geneesmiddelen (VIG). ‘Achter elk getal schuilt een patiënt die geen werkend medicijn meer had.’
Doelen uit zicht
Europa heeft zichzelf duidelijke doelen gesteld voor 2030: minder gebruik van antibiotica, minder resistente infecties en meer inzet van eerstekeusmiddelen uit de zogenoemde Access-groep . Maar de nieuwe ECDC-data wijzen niet in die richting.
Sinds 2019 is het aantal bloedbaaninfecties door resistente bacteriën juist flink gestegen. Zo nam het aantal infecties met Klebsiella pneumoniae die ongevoelig zijn voor carbapenems toe met meer dan zestig procent, terwijl er juist een afname van vijf procent was beoogd. En ook het antibioticagebruik is toegenomen in plaats van afgenomen.
Stapeling van oorzaken
De redenen voor de toenemende resistentie zijn bekend en moeilijk weg te nemen. Europa vergrijst, waardoor steeds meer mensen met chronische ziekten leven en vaker zorg gebruiken. Daarnaast verspreiden bacteriën zich razendsnel over landsgrenzen. En gemiddeld genomen is er op Europees niveau nog altijd sprake van overmatig antibioticagebruik, zowel in ziekenhuizen als daarbuiten.
‘Als een antibioticum te vaak wordt gebruikt, kunnen bacteriën er ongevoelig voor worden’, licht Bertens toe. ‘Mensen kunnen dan ernstig ziek worden van relatief onschuldige infecties of er zelfs aan overlijden. Het is daarom belangrijk om terughoudend te zijn met het gebruiken van antibiotica. Daarin loopt Nederland echt voorop.’
Weinig nieuwe antibiotica
‘Maar het mooiste is natuurlijk om te voorkomen dat mensen een infectieziekte oplopen. Dan denk ik aan preventieve maatregelen’, vervolgt Bertens. ‘Dat begint met hele basale zaken als toegang tot schoon water en goede riolering. Maar ook het inzetten van vaccins kan heel veel leed voorkomen, zoals we zien met bijvoorbeeld difterie of tuberculose. En daarnaast is het essentieel dat we nieuwe antibiotica ontwikkelen.’
‘Zonder nieuwe antibiotica verliezen we de basis van onze gezondheidszorg’, aldus Bertens. ‘Dan lopen we het risico terug te vallen naar een tijd waarin patiënten dood gingen aan een eenvoudige wond of een longontsteking. Dat mogen we niet laten gebeuren. We hebben beleid nodig dat innovatie stimuleert.’
Innovatie stimuleren
Voor deze stilstand in innovatie zijn verschillende oorzaken, maar één van de belangrijkste is het ontbreken van een verdienmodel voor ontwikkelaars. Succesvolle middelen worden uit voorzorg spaarzaam voorgeschreven, waardoor de opbrengsten laag blijven. ‘Medisch gezien heel logisch, maar tegelijkertijd remt dit onbedoeld wel investeringen in onderzoek en ontwikkeling’, licht Bertens toe.
‘Op zich worden er vrij veel investeringen gedaan om het onderzoek naar nieuwe antibiotica te stimuleren. Dat is nuttig en noodzakelijk, maar onvoldoende. We moeten als samenleving ook echt kijken naar manieren om uitontwikkelde antibiotica op de markt te houden, ook als ze weinig worden voorgeschreven. Zolang het financieel risico volledig bij bedrijven ligt, blijven nieuwe antibiotica uit’, waarschuwt Bertens.
Drieslag nodig
Het ECDC pleit voor een drieslag om antibioticaresistentie te bestrijden: verstandig gebruik van bestaande antibiotica, consequente infectiepreventie en een sterke focus op innovatie. Daarin speelt Europese samenwerking een sleutelrol; van gezamenlijke surveillance tot investeringen in onderzoek en productiecapaciteit.
‘Gerichte stimulansen voor antibiotica-innovatie zijn noodzakelijk om wetenschappelijke vooruitgang mogelijk te maken en patiënten te beschermen tegen infecties die opnieuw levensbedreigend kunnen worden’, besluit Bertens. ‘Beleidsmakers, zorginstellingen en de geneesmiddelensector dragen samen verantwoordelijkheid om het tij te keren.’
Verder lezen
Persbericht ECDC: Time to act and not react: how can the European Union turn the tide of antimicrobial resistance?